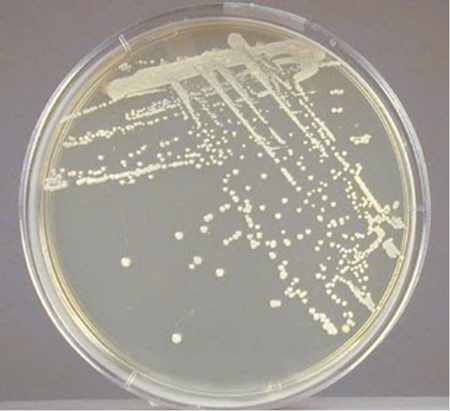
image 11
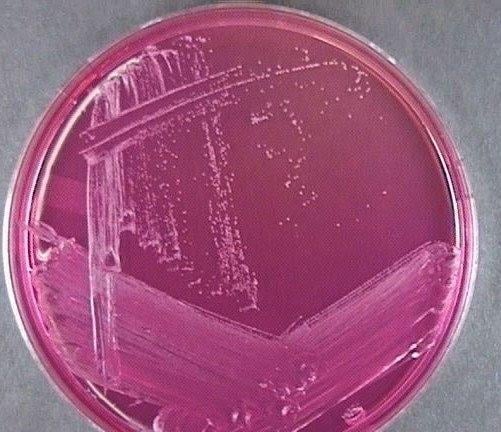
image 9
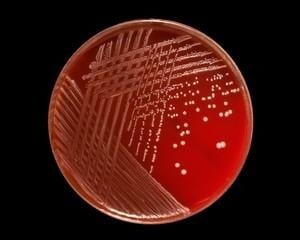
image 6

Staphylococcus epidermidis is a coagulase-negative, gram-positive cocci bacteria that forms clusters. It is a common symbiont bacterium that can become infectious once inside the human host. They are the most common coagulase-positive Staphylococcus species that live in human skin.

In its natural environment such as human skin or mucosa, they are usually harmless. These bacteria can produce biofilms when they invade the human host that help them with protection against the host defense or antimicrobials. Staphylococcus epidermidis is one of the most common causes of nosocomial infection, with infection rates as high as those of S. aureus.
Taxonomic Classification Level of Staphylococcus epidermidis
Domain: Bacteria
Phylum: Bacillota
Class: Bacilli
Order: Bacillales
Family: Staphylococcaceae
Genus: Staphylococcus
Species: Staphylococcus epidermidis
Classification of species of the genus Staphylococcus is based on various factors like the chemical properties of the cell wall, especially the amino acid composition and sequence of the interpeptide bridges of the peptidoglycan and teichoic acid composition.
Morphology and Microscopy of Staphylococcus epidermidis
Staphylococci are known as clustering Gram-positive cocci, nonmotile, non-spore forming facultatively anaerobic bacteria that are classified into two main groups; coagulase-positive and coagulase-negative Staphylococci. They are approximately 0.5-1.5µm in diameter on light microscopy. S. epidermidis belongs to the group of coagulase-negative staphylococci (CoNS), which is distinguished from coagulase-positive staphylococci such as S. aureus.
The cells of S. epidermidis are considered cell wall deficient or defective hence why they fail to take Gram stain and are not easily cultured on the usual isolation media. The cell wall is made up of peptidoglycan and teichoic acid where the PEG is the main structural polymer in the wall and plays a vital role in maintaining the spherical shape of the cell.

https://www.researchgate.net/figure/Microscopic-examination-of-S-epidermidis_fig2_348273291
Colonies of S. epidermidis grown on nutrient agar appear small, round, convex and typically white or grayish white in colour which are often called as cohesive and smooth. On blood agar, colonies are non-hemolytic after overnight incubation and measure about 1-2 mm in diameter under standard laboratory conditions, which assists in differentiation from other staphylococcal species with hemolytic activity.
Source: https://open.maricopa.edu/redmountainmicro/chapter/staphylococcus/
Cultural and Growth Characteristics of Staphylococcus epidermidis
S. epidermidis is a facultative anaerobic, non-fastidious organism that grows readily on routine laboratory media under standard incubation conditions (35-37°C for 18-24 hours).
On Nutrient Agar, colonies are typically small, circular, smooth, convex and opaque with no grayish colouration. The surface texture is usually butyrous and cohesive which is consistent with other members of the genus Staphylococcus.
On Blood Agar, S. epidermidis produces non-hemolytic colonies i.e. there is no visible lysis of red blood cells surrounding the colonies. This characteristic helps in differentiating it from hemolytic species such as S. aureus, which commonly exhibits β-hemolysis.
On Mannitol Salt Agar (MSA), S. epidermidis demonstrates good growth due to its halotolerance (agar has 7.5% sodium chloride), a defining characteristic of staphylococci. However, it does not ferment mannitol and therefore the medium remains pink or red without a colour change to yellow like in S. aureus. This selective and differential property in MSA is routinely used for laboratory identification.
S. epidermidis is a facultative anaerobe; it primarily utilizes aerobic respiration when oxygen is available but can shift to fermentative metabolism under anaerobic conditions. This flexibility in their metabolism supports their survival on human skin and medical devices where oxygen availability may vary.
The organism exhibits its optimal growth at temperatures between 30-37°C, with 37°C being ideal under laboratory conditions- they are mesophilic. Their growth typically becomes visible within 18-24 hours of incubation. S. epidermidis can tolerate a relatively broad range of temperature but does not grow well at extreme temperatures.
One of the key characteristics is its halotolerance. S. epidermidis can grow in media containing up to 7.5% sodium chloride which is the basis for its growth in MSA. This characteristic reflects adaptation to the high-salt environment of human skin.
S. epidermidis grows optimally at neutral to slightly alkaline pH, 7.0-7.5, although it can tolerate minor fluctuations.
These organisms are capable of forming biofilms, particularly on synthetic and indwelling medical devices. Biofilm production enhances bacterial adherence and promotes persistent growth under both aerobic and low-nutrient conditions. This is especially important in clinical settings, where it contributes to chronic device-associated infections.
https://www.medical-labs.net/staphylococcus-epidermidis-on-mannitol-agar-574/
https://www.microbiologyinpictures.com/bacteriainphotos/bacteria-under-microscope/staphylococcus-epidermidis-microscopy.html
Epidemiology of S. epidermidis
S. epidermidis is a symbiont that is harmless in its natural environment. However, it is an opportunistic pathogen that can cause virulence once it invades the human body via medical and prosthetic devices. These organisms are among the most common causes of nosocomial blood infections. Patients with prosthetic valves, cardiac devices, central lines, catheters and IV drug users are at most risk of being infected with these species. It is also highly prevalent among neonates.
Bacteremia from the S. epidermidis and other coagulase-negative staphylococcus species arise most commonly by indwelling medical device contamination. When placing a prosthetic device in a human body, the bacteria from the human skin can colonize the medical devices and enter the bloodstream.
Pathogenesis and Virulence of S. epidermidis
Pathogenesis
S. epidermidis is primarily an opportunistic pathogen causing disease when the skin barrier is breached or when foreign materials such as intravascular catheters, prosthetic joints or cardiac devices are introduced.
The central mechanism of its pathogenesis is production of the biofilm. Biofilm formation occurs with initial adhesion to a foreign surface or endothelium, which leads to accumulation into multicellular structures. The initial attachment is mediated by surface adhesins which bind to host extracellular matrix proteins coating implanted devices. Subsequent accumulation and maturation of biofilm involve the production of polysaccharide intracellular adhesin (PIA), encoded by the ica operon which facilitates adhesion and structural stability of the biofilm produced. The biofilm protects the organism against host defense via protective exopolymers called poly-y-glutamic acid.
Other exotoxins and endotoxins also appear to cause immune reaction and virulence inside the host.
Virulence
Although S. epidermidis is less virulent than S. aureus, it possesses several important virulence factors that enable persistence in clinical settings.
- Biofilm formation
Biofilm formation is the most important virulence factor or S. epidermidis. It supports colonization, immune evasion as well as antibiotic resistance of the organism. The formation of biofilms provides an advantage to the organism where it can better adapt to the environmental factors and has increased resistance to hostile conditions. It is achieved by two steps, the first being initial attachment of the bacteria followed by subsequent aggregation and maturation onto multicellular structures. S. epidermidis has surface proteins like AtlE, which is a bifunctional adhesin/autolysin and the Bap/Bhp protein that contributes to adhesion of bacteria to biotic and abiotic surfaces. Other surface proteins that are contained by S. epidermidis are called MSCRAMMs (Microbial surface components recognizing adhesive matrix molecules) that have the ability to interact with matrix proteins and support colonization.

https://doi.org/10.3389/fmicb.2017.01401
- Protective exopolymers
S. epidermidis produces exopolymers namely poly-y-glutamic acid (PGA) and PNAG/PIA that protect from important mechanisms of innate host defense. This exopolysaccharide has also been found to protect S. epidermidis from neutrophil killing, complement deposition and immunoglobulins.
- Pathogen-associated molecular patterns
Several molecules that are specific to S. epidermidis are also found to stimulate the innate host defense and hence act as pathogen-associated molecular patterns (PAMPs). The PNAG/PIA is reported to stimulate Toll-like receptor 2, which represents an interesting example to the hide-and-seek interplay between pathogen and host, as a substance that S. epidermidis uses for immune evasion would trigger innate host defense mechanism.

https://doi.org/10.3389/fmicb.2017.01401
Clinical Manifestations
S. epidermidis is commensal and widespread on humans, but can cause a variety of clinical infections when breaching the skin. It is a leading cause of catheter-related bloodstream infections. It can manifest in many ways once inside the human host, including localized and systematic infections.
Intravascular Catheter Infections
S. epidermidis and other CoNS are one of the leading causes of catheter-related bloodstream infection. The infection largely occurs as the bacteria migrate from the patients’ skin to the surface of the catheter but they can also migrate via luminal surfaces. For patients with catheter infection, they may present with localized symptoms such as inflammation, erythema or purulence around the insertion of catheter. They can also present with systemic signs like fever, hypotension and other signs concerning sepsis.
Infectious Endocarditis
S. epidermidis ranks as one of the most common species to cause infective endocarditis in both prosthetic valve and the native valve. Up to 40% of the cases of prosthetic valve endocarditis (PVE) are due to coagulase-negative staphylococci. Once the bacteria produce biofilm within the cardiac valves, it can accumulate and form vegetations. Patients with endocarditis can present with fever, chills, malaise, night sweats and dyspnea. The patient can also present with cardiac murmurs along with petechiae and/or splinter hemorrhages on physical exams.
Cardiac Devices, Prosthetic Joints and CNS Shunt Infection
S. epidermidis can cause infections from implantation of medical devices such as cardiac devices, orthopedic devices and CNS shunt. Shunt infection may present without symptoms, but can also cause headache, dizziness, nausea, vomiting and altered mental status.
Bone System Interactions
Chronic S. epidermidis osteomyelitis induces persistent inflammation in bone, particularly in orthopedic device-related infections. Pro-inflammatory cytokines such as TNF-α, IL-1β and IL-6 stimulate osteoclast activity, leading to increased bone resorption. At the same time, these cytokines impair osteoblast function, reducing new bone formation. The combined effect results in progressive osteolysis at the site of infection.

https://doi.org/10.3389/fmicb.2017.01401
Laboratory Diagnosis
Specimens: swabs from the infected sites, joints aspirations and blood; catheter tips, prosthetic material, etc.
Direct microscopy following gram staining typically reveals gram-positive cocci arranged in clusters. Hence, culture in selective, differential media is crucial.
Culture
Culture on routine media such as blood agar produces small, white, non-hemolytic colonies after 18-24 hours of incubation at 35–37 °C.
Growth on MSA confirms halotolerance even though the fermentation of mannitol is usually negative.
The organism is catalase positive and coagulase negative, which differentiates it from Staphylococcus aureus.
Molecular methods for identification
Molecular identification of S. epidermidis relies on nucleic-acid based techniques that provide rapid and accurate species-level confirmation. Polymerase chain reaction (PCR) targeting conserved genes such as the 16S rRNA gene is usually used for genus level detection while species specific targets including tuf, rpoB and soda genes improve discrimination among coagulase-negative staphylococci.
In clinical microbiology laboratories, MALDI-TOF mass spectrometry is widely used fro rapid species identification based on protein spectral analysis offering high accuracy and turnaround time compared to conventional biochemical methods.
Treatment
Treatment for S. epidermidis largely depends on the type and severity of the infection.
- Patients with systemic infection warrant parenteral therapy
- The choice of empiric therapy for S. epidermidis infection would be IV vancomycin as methicillin resistance should be assumed
- If the pathogen is methicillin susceptible, treatment can be narrowed to beta-lactam antibiotics such as nafcillin and oxacillin
- The duration of therapy depends on the clinical presentation
- Prosthetic and medical devices require removal to control the source of infection
Sepsis and septic shock are complications with high mortality that can arise with catheter-related infections. The mortality rate for septic shock can be up to 20 to 30%. Prosthetic valve endocarditis or native valve endocarditis can lead to complications including septic emboli, myotic aneurysm, perivalvular abscess and heart failure.
Prevention
Prevention of Staphylococcus epidermidis infections focuses in minimizing healthcare-associated risks, particularly in patients with indwelling medical devices:
- Strict aseptic technique during insertion and handling of catheters, prosthetic devices and surgical implants
- Regular surveillance and hand hygiene among healthcare workers to reduce transmission of skin associated staphylococci
- Coating of biomaterials with antimicrobials or use in exit-site dressings to be employed to prevent medical devices related infections
- Appropriate prophylactic antibiotics during surgery when indicated
These measures combined with surveillance and antimicrobial stewardship helps in controlling the spread and clinical impact of S. epidermidis infections.
Conclusion
S. epidermidis is a ubiquitous skin commensal that acts as an opportunistic pathogen, particularly in healthcare associated and device related infections. Its pathogenicity relies on formation of biofilm, immune evasion and antimicrobial resistance. Laboratory diagnosis combines culture, biochemical tests and molecular methods for accurate identification, while antimicrobial susceptibility testing can be used to guide therapies. Prevention and control focuses on strict techniques, device managements and infection control measures to reduce colonization and transmission.
References
- ASM Journals. (2014). Becker, K., Heilmann, C., & Peters, G. Coagulase-negative staphylococci. Clinical Microbiology Reviews, 27(4), 870–926. https://journals.asm.org/doi/10.1128/cmr.00109-13
- Frontiers in Microbiology. (2017). Staphylococcus epidermidis: Insights into biofilm formation and pathogenicity. https://www.frontiersin.org/journals/microbiology/articles/10.3389/fmicb.2017.01401/full
- George Washington University Office of Research Safety. (n.d.). Staphylococcus epidermidis (S. epidermidis). https://researchsafety.gwu.edu/pathogen-data-sheets/staphylococcus-epidermidis-s-epidermidis
- Maricopa Open Digital Press. (n.d.). Staphylococcus. https://open.maricopa.edu/redmountainmicro/chapter/staphylococcus/
- Medical Labs. (n.d.). Staphylococcus epidermidis on mannitol agar. https://www.medical-labs.net/staphylococcus-epidermidis-on-mannitol-agar-574/
- Microbe Notes. (n.d.). Staphylococcus epidermidis. https://microbenotes.com/staphylococcus-epidermidis/#classification-of-staphylococcus-epidermidis
- Microbiology in Pictures. (n.d.). Staphylococcus epidermidis colony morphology. https://www.microbiologyinpictures.com/bacteriainphotos/staphylococcus_epidermidis_colony_morphology.html?utm_source=chatgpt.com
- Microbiology in Pictures. (n.d.). Staphylococcus epidermidis microscopy. https://www.microbiologyinpictures.com/bacteriainphotos/bacteria-under-microscope/staphylococcus-epidermidis-microscopy.html
- NCBI Bookshelf. (2024). Staphylococcus epidermidis infection. StatPearls Publishing. https://www.ncbi.nlm.nih.gov/books/NBK563240/
- ResearchGate. (2021). Microscopic examination of S. epidermidis. https://www.researchgate.net/figure/Microscopic-examination-of-S-epidermidis_fig2_348273291
- Wikipedia contributors. (2024, January 24). Staphylococcus epidermidis. Wikipedia. https://en.wikipedia.org/wiki/Staphylococcus_epidermidis?utm_source=chatgpt.com
